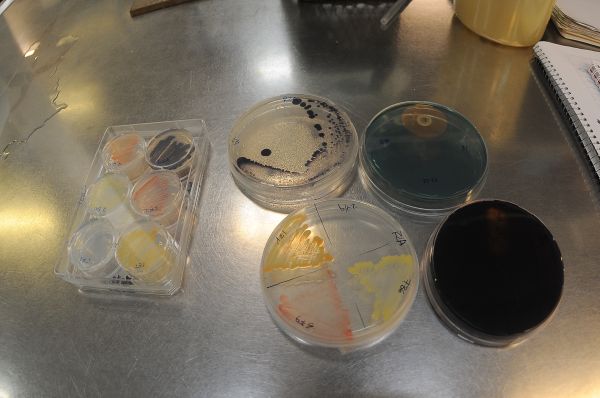
El eterno femenino de una imaginativa pintora

La respuesta inmune de los enfermos con lupus mejora si se trabaja sobre las bacterias presentes en su organismo, probó un estudio de la Universidad de Oviedo (norte de España) y del español Consejo Superior de Investigaciones Científicas.
El lupus es una enfermedad autoinmune crónica que conlleva gran variedad de síntomas clínicos, como manifestaciones cutáneas, articulares y renales.
Gracias a un método que permite separar las bacterias intestinales del resto de contenido fecal, añadieron bacterias beneficiosas para el cuerpo como las Bifidobacterium bifidum, Ruminococcus obeum y Blautia coccoides.
"Hemos comprobado que cuando estas bacterias se ponen en contacto con las células inmunes se corrige parcialmente el desequilibrio inmunológico que padecen las personas con lupus", explicó el investigador Abelardo Margolles.
SALUD